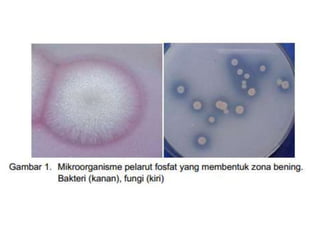

Mikroba pelarut fosfat (MPF) adalah mikroorganisme yang dapat melarutkan fosfat anorganik tanah menjadi bentuk yang dapat diserap tanaman. MPF terdiri atas bakteri dan fungi pelarut fosfat yang umumnya berada di tanah dekat akar tanaman. MPF melarutkan fosfat melalui ekskresi asam organik atau enzim fosfatase dan fitase. Isolasi MPF dapat dilakukan dari tanah miskin fosfat dengan metode cawan petri